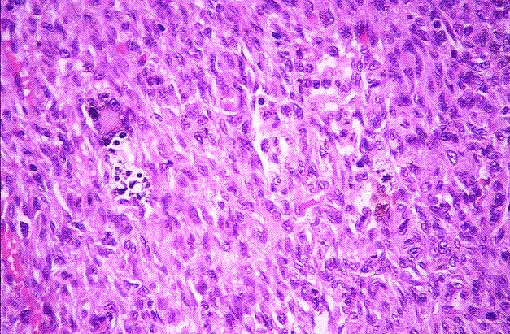
Fig 4

Póster
Nş 072
Póster |
José MŞ Martínez de Victoria Muńoz, César Ramirez Tortosa, Isabel Ruiz Avila; Eulalia Bernet Vegue; Cristobal Cueva Ruiz, Angel Carazo Tirao.
 |
| Fig 1.- Aspecto aneurismático del tumor que muestra hiperplasia epidérmica asociada. (H&E, 40x). |
 |
| Fig 2.- En la periferia de la lesión se observan haces de colágeno hialinizados rodeados por células tumorales. (H&E, 100x). |
 |
| Fig 3.- Aspecto angiomatoide del tumor, aunque los espacios vasculares carecen de revestimiento endotelial. (H&E, 200x) |
|
| Fig 4.- La lesión muestra polimorfismo celular con presencia de células gigantes y depósitos de hemosiderina. (H&E, 200x). |